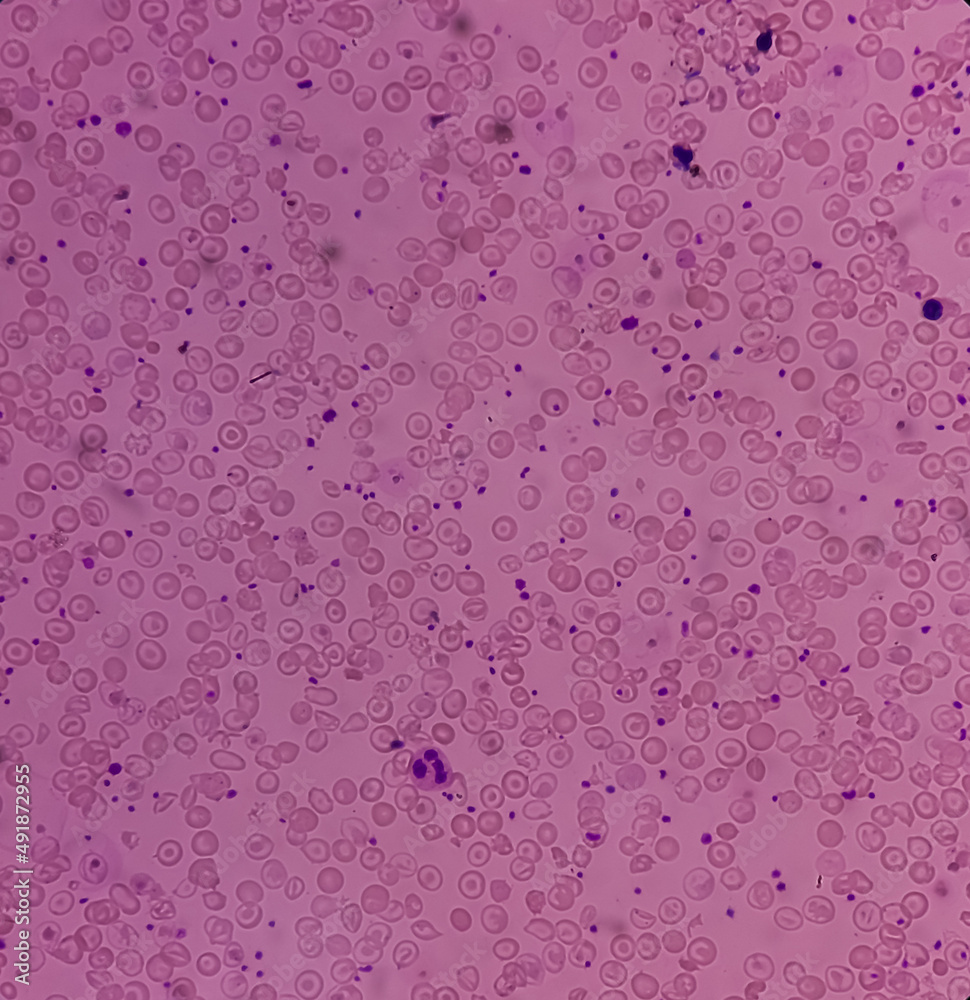
Hereditary hemolytic anemia with thrombocytosis, inherited blood

La hemólisis (eritrocateresis) es el fenómeno de la desintegración de los eritrocitos (glóbulos rojos o hematíes).
El eritrocito carece de núcleo y orgánulos, por lo que no puede repararse y muere cuando se «desgasta». Este proceso está muy influido por la tonicidad del medio en el que se encuentran los eritrocitos.
Por ejemplo, en una solución hipotónica con respecto al eritrocito, este pasa por un estado de hemólisis (se hincha por el exceso de líquido) y luego esta célula estalla debido a la presión.
Esto genera una menor cantidad de células que transporten oxígeno al cuerpo entre otros elementos como los anticuerpos.
Aproximadamente un 85 % de los eritrocitos se destruyen extravascularmente, es decir, sin liberar su hemoglobina al plasma. Se produce en el bazo y en menor medida en el hígado y la médula ósea.
Se produce al final de la vida media de los eritrocitos, aproximadamente a los 120 días.[1]
En determinadas situaciones patológicas hay un aumento de la destrucción de los eritrocitos intra o extravascular, como consecuencia de:
- Unión antígeno-anticuerpo (reacción transfusional, enfermedad hemolítica del recién nacido).
- Lesiones mecánicas (como en el fallo de las prótesis de válvula cardíaca).
- Trastornos osmóticos.
- Trastornos enzimáticos.
- Trastornos tóxicos por hemotoxinas.
- Alteraciones congénitas de los eritrocitos (en anomalías de la hemoglobina o en infecciones).
- Infecciones como la malaria.
Causas en el manejo de muestras
La hemólisis puede ser provocada por diferentes causas como:
- Exceso de velocidad de succión de la muestra.
- Uso de agujas, jeringas y/o recipientes húmedos.
- Vaciado inadecuado de la jeringa.
- Proporción inadecuada de anticoagulante.
- Mordedura de arañas de la familia Sicariidae y Latrodectus mactans.
- Mordedura de víboras y crótalos.
Los casos más severos de episodios hemolíticos se dan en pacientes con deficiencia de glucosa -6- fosfato deshidrogenasa expuestos a situaciones, fármacos o sustancias que precipiten el episodio, aunque normalmente los episodios son breves y de recuperación espontánea, debido a que el cuerpo continúa produciendo glóbulos rojos, en raras ocasiones se puede producir insuficiencia renal o la muerte después de unos eventos hemolíticos severos.
La hemólisis interfiere con las mediciones de potasio, LDH, fosfatasa ácida, GOT, GPT, bilirrubinas y creatinina, entre otras.
Este efecto también se produce en las personas que sufren ahogamiento en agua dulce, cuando el agua de los alvéolos pulmonares pasa a la corriente sanguínea ocurre la hemodilución.[cita requerida]
Véase también
- Eritrocito
- Alteraciones de los hematíes
- Síndrome urémico hemolítico
- Anemia hemolítica
Referencias